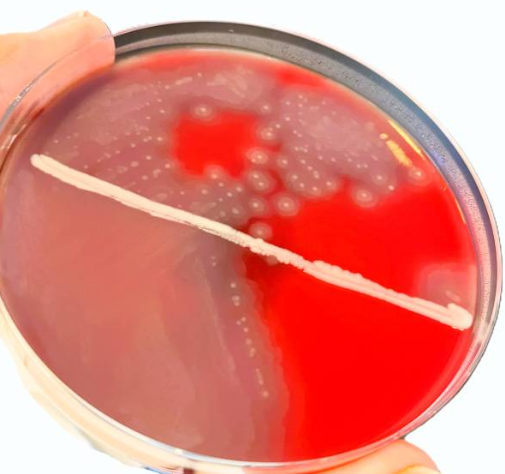

კალათა ცარიელია: 0,00 ₾
აიმაღლეთ ცოდნის დონე სქილიოს პლატფორმის მეშვეობით
გაეცანით გონივრულად
ექსპერტების შედგენილი
თავისუფალი წვდომა
საინფორმაციო მასალები
შეარჩიეთ თქვენთვის საინტერესო საკითხები და მიიღეთ ცოდნა, რომელიც ყოველდღიურ ცხოვრებაში დაგიცავთ თქვენ და საზოგადოებას

ლაიმის დაავადება (ბორელიოზი)
ლაიმის დაავადება ბაქტერიული ინფექციაა, რომელიც ადამიანებზე შავფეხა ტკიპების ნაკბენით ვრცელდება. უმეტეს შემთხვევაში, ლაიმის დაავადების გამომწვევის...
გაეცანი
როცა მიკრობის საწინააღმდეგო წამალი ვეღარ ებრძვის მიკრობს
ანტიმიკრობული რეზისტენტობა (ამრ) ვითარდება მაშინ, როდესაც მიკრობები იძენენ მათ გასანადგურებლად შექმნილი პრეპარატების დამარცხების უნარს.; ანტიბიკრობულ...
გაეცანი
ანტიმიკრობული რეზისტენტობის წარმოშობისა და გავრცელების კონტროლი
ანტიმიკრობული რეზისტენტობის წარმოშობისა და გავრცელების კონტროლი პროექტის დონორია სლოვაკეთის საერთაშორისო განვითარების თანამშრომლობის სააგენტო 26 ნახვა...
გაეცანი
ანტიმიკრობული რეზისტენტობის კონტროლი მეცხოველეობასა და მეფრინველეობაში
ცხოველების ნაწლავებში არიან მიკრობები, მათ შორის ანტიმიკრობული პრეპარატების მიმართ რეზისტენტული (ამრ).; რეზისტენტული მიკრობები გამოვლინდნენ მეფრინველეობასა...
გაეცანი
სამედიცინო პერსონალისა და ვეტერინარების მიერ ანტიმიკრობული რეზისტენტობის კონტროლი
ანტიმიკრობული რეზისტენტობის (ამრ) გავრცელებასთან ბრძოლის საქმეში, ყველას თავისი როლი აქვს შესასრულებელი.; ჩვენ შეგვიძლია მივიღოთ ზომები...
გაეცანი
მიკრობული ეკოლოგიის შესახებ
მიკრობები, ყველგან გვხვდება, მათ შორის ადამიანებზე, ცხოველებსა და გარემოში, სადაც ისინი თანაცხოვრობენ და წარმოქმნიან ერთიანობას,...
გაეცანი
მუნი (Scabies)
მუნი - ეს არის კანის პარაზიტული ინვაზია, რომელსაც იწვევს მიკროსკოპული ტკიპა . მისთვის დამახასიათებელია ძლიერი...
გაეცანი
რეზისტენტობის მიზეზები და გავრცელება
ანტიმიკრობული პრეპარატების მიმართ რეზისტენტული მიკრობები ვრცელდება სამედიცინო დაწესებულებებში და მათ შორის, ანტიბიოტიკების და სოკოს საწინააღმდეგო...
გაეცანი
ხელის ჰიგიენა
ხელის ჰიგიენა - ეს არის ხელების გაწმენდის აქტი ჭუჭყის და მიკროორგანიზმების მოსაშორებლად. იგი აღიარებულია ინფექციების...
გაეცანი
ხელის ჰიგიენა – ხშირად დასმული კითხვები
ხელის ჰიგიენა - ეს არის ხელების გაწმენდის აქტი ჭუჭყის და მიკროორგანიზმების მოსაშორებლად. იგი აღიარებულია ინფექციების...
გაეცანი
სამედიცინო მომსახურებასთან ასოცირებული (სმა) ინფექციები
სამედიცინო მომსახურებასთან ასოცირებული (სმა) ინფექცია - არის ჯანდაცვის დაწესებულებაში სამედიცინო დახმარების პროცესში შეძენილი ჯანმრთელობის დამატებითი...
გაეცანი
ოპერაციის შემდგომი ჭრილობის ინფექცია
ოპერაციის შემდგომი ჭრილობის ინფექცია - ეს არის ინფექცია, რომელიც თავს იჩენს ოპერაციის შემდგომ სხეულის იმ...
გაეცანი
სისხლის ნაკადის ინფექციების პრევენციის საუკეთესო პრაქტიკა დიალიზისას
აშშ დაავადებათა კონტროლის ცენტრის რეკომენდაციები, რომლებიც ცნობილია როგორც ძირითადი ინტერვენციები, წარმოადგენს სისხლის ნაკადის ინფექციების პრევენციის...
გაეცანი
დიალიზზე მყოფი პაციენტები და ინფექციები
დიალიზზე მყოფი პაციენტები ინფექციების რისკის ქვეშ არიან; დიალიზის მკურნალობის თითოეულ ვარიანტს ინფექციის განსხვავებული რისკები აქვს;...
გაეცანი
რჩევები პაციენტის უსაფრთხოებისთვის
სამედიცინო დაწესებულებაში პაციენტის უსაფრთხოების დაცვა მკურნალობის პროცესში ამცირებს დაავადებების რისკებს.; პაციენტები, მომვლელები და სამედიცინო პერსონალი...
გაეცანი
ვაქცინაცია და მისი სარგებელი
ვაქცინაცია - ეს არის დაავადებებისგან დაცვის მარტივი, უსაფრთხო და ეფექტური ბიოლოგიური პრეპარატი. ის არის ორგანიზმის...
გაეცანი
ვაქცინაცია – ხშირად დასმული კითხვები
ვაქცინაცია - ეს არის დაავადებებისგან დაცვის მარტივი, უსაფრთხო და ეფექტური ბიოლოგიური პრეპარატი. ის არის ორგანიზმის...
გაეცანი
B ჯგუფის სტრეპტოკოკის შესახებ ინფორმაცია ორსულებისთვის
ყოველი ორსულობის დროს ქალებმა უნდა ჩაატარონ სკრინინგი B ჯგუფის სტრეპტოკოკზე (B ჯგუფის სტრეპტოკოკი, GBS); ტესტი...
გაეცანი
ორსულთა ვაქცინაცია
ქვემოთ მოცემულ ცხრილში შეჯამებულია ორსული ქალების რუტინული, მოგზაურობის დროს გამოსაყენებელი და სხვა კონკრეტულ სიტუაციაში გამოსაყენებელი...
გაეცანი
ძუძუთი კვების შესახებ – ლაქტაცია
ძუძუთი კვება ჩვილების უმეტესობისთვის საკვების მიღების საუკეთესო წყაროა; ძუძუთი კვებას შეუძლია შეამციროს გარკვეული ჯანმრთელობის პრობლემების...
გაეცანი
ინფორმაცია ორსულებისთვის – გესტაციური დიაბეტი
გესტაციური დიაბეტი შეიძლება განვითარდეს ორსულობის დროს ქალებში, რომლებსაც ჯერ არ აქვთ დიაბეტი.; ის, როგორც წესი,...
გაეცანი
მძიმე დიარეა (C. diff ინფექცია)
C. diff არის ტოქსინის გამომყოფი ბაქტერია, რომელსაც შეუძლია გამოიწვიოს როგორც მსუბუქი დიარეა, ისე ადამიანის მსხვილი...
გაეცანი
სჭირდება თუ არა ანტიბიოტიკები ჩემს შვილს სურდოს დროს?
სჭირდება თუ არა ჩემს შვილს ანტიბიოტიკები სურდოს დროს? კითხვები და პასუხები მშობლებისთვის პროექტის დონორია სლოვაკეთის...
გაეცანი
მწვავე ბრონქიტი
შესაძლოა, თქვენ გაქვთ მწვავე ბრონქიტი; თუმცა, გაითვალისწინეთ: ანტიბიოტიკები განკურნებაში არ დაგეხმარებათ
გაეცანი
ყურის ინფექციები ბავშვებში
ეს შესაძლოა ყურის ინფექცია იყოს. ბავშვებში ყურის ინფექციები უფრო ხშირია, ვიდრე მოზრდილებში. გაესაუბრეთ პედიატრს თქვენი...
გაეცანი
კანის ინფექციები
შესაძლოა, ეს კანის ინფექცია იყოს; კანის ინფექციის შემთხვევაში სამედიცინო პერსონალი განსაზღვრავს, გჭირდებათ თუ არა ანტიბიოტიკი
გაეცანისაზოგადოების გამოხმაურება სქილიოზე
ნახეთ, რას ამბობენ ჩვენი პლატფორმის მომხმარებლები იმაზე, თუ როგორ დაეხმარათ მიღებული ცოდნა ყოველდღიურ ცხოვრებაში.
სქილიოს მომხმარებლები პლატფორმიდან მიღებულ ინფორმაციას დადებითად და საჭიროდ აფასებენ
აღნიშნავს, რომ პლატფორმამ გაზარდა მათი ცნობიერება ინფექციების პრევენციის საკითხებში

ანა კუცია